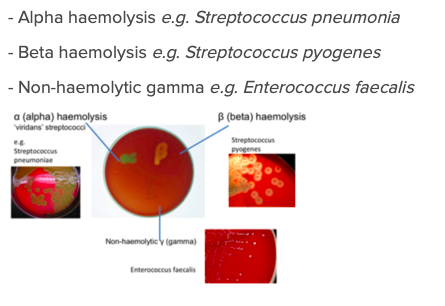

What are the shape of streptococci?
Gram positive cocci chains
String of pearls

How are streptococci classified into three groups by haemolysis?
- Alpha/Viridans (Green) : partial haemolysis
- Beta (White) : complete haemolysis
- Gamma: no haemolysis
What are Viridans streptococci?
What else can streptococci be identified as apart from haemolysis?
What infection does strep pyogenes normally cause?
What shape and gram are staphylococcus?
- Clustered gram positive cocci

Identify and describe 3 virulence factors of streptococcus pyogenes.

What is the full name and classification of Strep.Pyogenes?
Lancefield Group A Beta-Haemolytic Streptococcus
What is streptococcal pharyngitis?

What are some complications of streptococcal pharyngitis?

What is scarlet fever?
Acute condition

What is acute rheumatic fever?
Causes inflammation of own tissues

What are some symptoms of rheumatic fever?

What is acute post-streptococcal glomerulonephritis?

What are some skin infections that Strep.Pyogenes can cause?
What is impetigo?

What is erysipelas?

What is cellulitis?

What is necrotising fascitis?

What is toxic shock syndrome?

What is the pathogenesis of toxic shock syndrome?

What is the coagulase test?
Clotting means Staph Aureus

What is vegetation?

What is a biofilm?
Microbial communities attached to surfaces and encased in an extracellular matrix of microbial origin